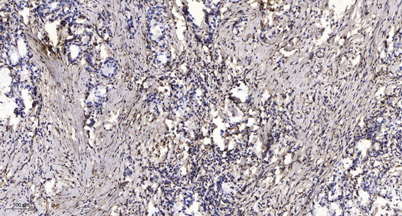

$148.00/50µL $248.00/100µL
| 50 µL | $148.00 |
| 100 µL | $248.00 |
| Product name: | CYP24A1 rabbit pAb |
| Reactivity: | Human;Rat;Mouse; |
| Alternative Names: | CYP24A1; CYP24; 1; 25-dihydroxyvitamin D(3) 24-hydroxylase, mitochondrial; 24-OHase; Vitamin D(3) 24-hydroxylase; Cytochrome P450 24A1; Cytochrome P450-CC24 |
| Source: | Rabbit |
| Dilutions: | Western Blot: 1/500 - 1/2000. Immunohistochemistry: 1/100 - 1/300. ELISA: 1/10000. Not yet tested in other applications. |
| Immunogen: | The antiserum was produced against synthesized peptide derived from human Cytochrome P450 24A1. AA range:411-460 |
| Storage: | -20°C/1 year |
| Clonality: | Polyclonal |
| Isotype: | IgG |
| Concentration: | 1 mg/ml |
| Observed Band: | 38kD |
| GeneID: | 1591 |
| Human Swiss-Prot No: | Q07973 |
| Cellular localization: | Mitochondrion . |
| Background: | cytochrome P450 family 24 subfamily A member 1(CYP24A1) Homo sapiens This gene encodes a member of the cytochrome P450 superfamily of enzymes. The cytochrome P450 proteins are monooxygenases which catalyze many reactions involved in drug metabolism and synthesis of cholesterol, steroids and other lipids. This mitochondrial protein initiates the degradation of 1,25-dihydroxyvitamin D3, the physiologically active form of vitamin D3, by hydroxylation of the side chain. In regulating the level of vitamin D3, this enzyme plays a role in calcium homeostasis and the vitamin D endocrine system. Alternatively spliced transcript variants encoding different isoforms have been found for this gene. [provided by RefSeq, Jul 2008], |